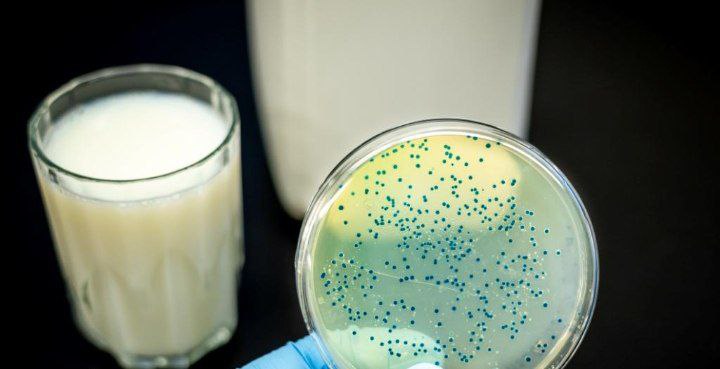

🔶Brutsellyoz diagnostikasi va davolash 🔶Brutsellyoz diagnostikasi klinik baholash va simptomlar asosida laboratoriya tekshiruvlari orqali amalga oshiriladi. Tana suyuqliklarida yoki to’qimalar namunalarida bakteriyalar mavjudligini aniqlash uchun qon testi o’tkaziladi. Ushbu testlar kasallikning tashxisini tasdiqlashga va tegishli davolanishni boshlashga yordam beradi. 🔶Brutsellyozni davolash…

📌Gepatit C — antroponoz virusli kasallik, HCVning sababi jigarning yallig’lanishidir. 📌Tavsifi 📌Kasallikning ikki kechish turi farqlanadi:o’tkir va surunkali. 📌O’tkir gepatit C ning rivojlanishi virus bilan zararlangandan keyin boshlanadi. Bu vaqtda ko’pchilik kasallanganlarda hech qanday belgilar kuzatilmaydi. 📌Taxminan 50 — 80% bemorlarda kasallik keyinchalik surunkali…

#infografika «Ovqatdan zaharlanishning belgilari» Sanepidqoʻmita Qarshi tuman boʻlimi Axborot xizmati https://t.me/sanepidqom_qarshitum

✔️PTOZ (yun. ptosis-tushish) koʻz muskullarining falajlanishi natijasida yuqori qovoqning salqib tushishi. ✔️Tugʻma yoki hayotda orttirilgan boʻladi. ✔️Tugʻma Ptoz koʻpincha, nasldan-naslga oʻtadi, deyarli hamma vaqt ikkala koʻz qovogʻi tushadi. Yuqori qovoqni koʻtaruvchi muskulning rivojlanmay qolishi tugʻma Ptozga sabab boʻladi. ✔️Hayotda orttirilgan…

Sanepidqoʻmita Qarshi tuman boʻlimi xodimlari tomonidan Shodlik MFY hududida joylashgan «Qilichov Sunnat Toirovich»ga tegishli oilaviy nodavlat maktabgacha taʼlim tashkilotida Sogʻlom turmush tarzi,yuqumli parazitar kasalliklar,gepatit,botulizm va ovqatdan zaharlanish kasalliklari va ularni oldini olish boʻyicha targʻibot ishlari olib borildi. https://t.me/sanepidqom_qarshitum

✅Yoz mavsumida ovqatdan zaharlanishdan saqlaning! ✅Yoz mavsumi keldi!Bu davr tabiat bilan yaqinlashish, sayohat qilish va ochiq havoda vaqt o’tkazish uchun eng yaxshi vaqt. Ammo, shuningdek, ovqatdan zaharlanish xavfi ham oshadi. ✅Quyidagi maslahatlar yozda sog’lom va xavfsiz ovqatlanishingizni ta’minlaydi: ✅Sanitariya qoidalariga…

📌Korrupsiyaning jamiyatga zarari 📌Iqtisodiy ta’sir: Korrupsiya iqtisodiy o‘sishni to‘g‘rilashda jiddiy to‘siq bo‘lib xizmat qiladi.Korrupsiyaning yuqori darajasi investitsiyalarning kelishini cheklaydi va mahalliy biznesni rivojlantirishga to‘sqinlik qiladi. 📌Ijtimoiy ta’sir: Korrupsiya ijtimoiy adolatsizlikni kuchaytiradi.Korrupsiyaga yo‘l qo‘yilganda, resurslar notog‘ri taqsimlanadi va qashshoq qatlamlar zarar…
